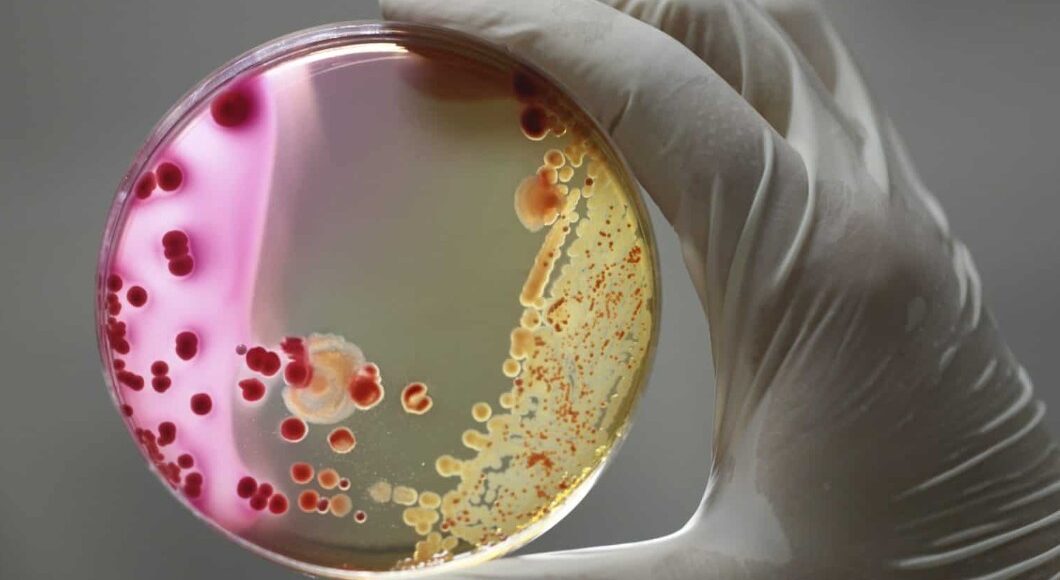
Uromed

Σταφυλόκοκκος : Συμπτώματα – θεραπεία – διάρκεια
Ο σταφυλόκοκκος είναι μια λοίμωξη από το βακτήριο Staphylococcus. Υπάρχουν περισσότεροι από 30 τύποι βακτηρίων του σταφυλόκοκκου.
- Ο χρυσίζων σταφυλόκοκκος (staph) είναι ένας τύπος μικροβίου που περίπου το 30% των ανθρώπων μεταφέρει στις μύτες τους.
- Τις περισσότερες φορές, ο σταφυλόκοκκος δεν προκαλεί καμία βλάβη, αλλά κάποιες φορές μπορεί να προκαλέσει λοιμώξεις.
- Το πιο συνηθισμένο ανθρώπινο παθογόνο είναι ο Staphylococcus aureus
- Ορισμένοι τύποι Staphylococcus aureus είναι ανθεκτικοί στις συνήθεις αντιβιοτικές θεραπείες.
- Σε ορισμένες περιπτώσεις, μια σταφυλοκοκκική λοίμωξη μπορεί να προκαλέσει πολύ σοβαρές επιπλοκές στην υγεία
Πόσο συχνή είναι μία λοίμωξη σταφυλόκοκκου;
Χιλιάδες δερματικές λοιμώξεις από σταφυλόκοκκο εμφανίζονται στην Ελλάδα κάθε χρόνο. Οι περισσότερες από αυτές είναι ήπιες και μπορούν να αντιμετωπιστούν με αντιβιοτικά. Ακόμα κι αν είστε υγιείς, τα βακτήρια του σταφυλόκοκκου συνήθως ζουν στη μύτη σας ή στο δέρμα. Εάν τα βακτήρια εισχωρήσουν στο σώμα μας, μπορούν να προκαλέσουν σοβαρά προβλήματα. Όταν εισχωρήσουν στο σώμα μας, δημιουργούν πολλές σοβαρές περιπτώσεις λοιμώξεων.
Τι είναι ο σταφυλόκοκκος

Περίπου το 20% των ενηλίκων φέρουν βακτήρια σταφυλόκοκκου στο δέρμα τους και περίπου το 30% στις ρινικές κοιλότητες.
Τα βακτήρια του σταφυλόκοκκου γενικά δεν προκαλούν βλάβη, εκτός αν εισέλθουν στο σώμα μέσω μιας πληγής. Όταν συμβεί αυτό, τα βακτήρια μπορούν να δημιουργήσουν ανοιχτές πληγές είτε στο δέρμα, είτε εσωτερικά. Αυτές οι συστηματικές λοιμώξεις μπορεί να είναι σοβαρές και ακόμη και θανατηφόρες.
Οι λοιμώξεις από σταφυλόκοκκο είναι μεταδοτικές. Το φτέρνισμα, ο βήχας ή το άγγιγμα μιας μολυσμένης πληγής μπορεί να μεταδώσει τη μόλυνση, αλλά πολλές περιπτώσεις συμβαίνουν όταν ένα άτομο έρχεται σε επαφή με ένα μολυσμένο αντικείμενο.
Η άμεση επαφή από άτομο σε άτομο με κάποιον που έχει τη λοίμωξη μπορεί επίσης να επιτρέψει τη μετάδοσή της.
Τύποι σταφυλοκοκκικής λοίμωξης
Τα βακτήρια του σταφυλόκοκκου μπορούν να προκαλέσουν μια ποικιλία λοιμώξεων, όπως:
- δερματικές λοιμώξεις, οι οποίες οδηγούν σε ανοικτές πληγές
- λοίμωξη της κυκλοφορίας του αίματος, γνωστή ως βακτηριαιμία
- λοίμωξη των οστών
- ενδοκαρδίτιδα, μια λοίμωξη του βλεννογόνου της καρδιάς
- τροφική δηλητηρίαση
- πνευμονία
- σύνδρομο τοξικού σοκ (TSS)
Τα αντιβιοτικά είναι αποτελεσματικές θεραπείες για τις περισσότερες λοιμώξεις από σταφυλόκοκκο.
Ωστόσο, υπάρχει ένας τύπος σταφυλόκοκκου που ονομάζεται ανθεκτικός στη μεθικιλλίνη Staphylococcus aureus (MRSA), ο οποίος είναι ανθεκτικός σε αρκετά αντιβιοτικά. Αυτή η μορφή μόλυνσης από σταφυλόκοκκο αποτελεί σημαντική ανησυχία για τη δημόσια υγεία.
Η θεραπεία πρώτης γραμμής για τον MRSA είναι η βανκομυκίνη, ένα αντιβιοτικό. Ωστόσο, τα τελευταία χρόνια έχουν εμφανιστεί ορισμένα στελέχη σταφυλόκοκκου ανθεκτικά στη βανκομυκίνη.
Οι λοιμώξεις από σταφυλόκοκκο μπορούν να προσβάλουν οποιαδήποτε περιοχή του δέρματος και, μόλις εισέλθουν στο σώμα μέσω μιας ανοιχτής πληγής, πολλά εσωτερικά συστήματα. Χωρίς θεραπεία, μπορεί να προκαλέσουν σηψαιμία.
Πώς εμφανίζεται η λοίμωξη
Αν και πολλοί άνθρωποι φέρουν βακτήρια σταφυλόκοκκου στο δέρμα ή στη μύτη τους, δεν αναπτύσσουν όλοι λοίμωξη. Η μόλυνση εμφανίζεται μόνο όταν τα βακτήρια σταφυλόκοκκου εισέρχονται στο δέρμα ή στο σώμα μέσω κοψίματος, εκδοράς, πληγής ή κατάποσης τροφής.
Τα βακτήρια του σταφυλόκοκκου μπορούν να μεταδοθούν σε ένα άτομο μέσω της επαφής δέρμα με δέρμα με κάποιον με τη μόλυνση.
Επομένως, η καλή υγιεινή είναι ο καλύτερος τρόπος για να αποφύγετε μια μόλυνση από σταφυλόκοκκο.
Ορισμένα βήματα που πρέπει να ακολουθήσετε περιλαμβάνουν:
- το σχολαστικό πλύσιμο των χεριών με σαπούνι και νερό
- την κάλυψη των τραυμάτων με καθαρούς, στεγνούς επιδέσμους
- την απόρριψη των επιδέσμων απευθείας στα σκουπίδια
- την αποφυγή του σκαλίσματος σπυριών ή εξογκωμάτων στο δέρμα
- την αποφυγή της κοινής χρήσης προσωπικών αντικειμένων, όπως πετσέτες, ξυραφάκια και πετσέτες πλύσης
Συμπτώματα
Τα συμπτώματα μιας λοίμωξης από σταφυλόκοκκο ποικίλλουν ανάλογα με τον τύπο της λοίμωξης και μπορεί να περιλαμβάνουν:
- Λοιμώξεις του δέρματος: Αυτές μπορεί να δημιουργήσουν εξογκώματα ή πληγές που μπορεί να πρηστούν ή να είναι επώδυνες. Μπορεί να περιέχουν πύον ή άλλο υγρό και μπορεί να σχηματιστεί κρούστα. Μπορεί να εμφανιστεί κυτταρίτιδα, κατά την οποία το δέρμα αποχρωματίζεται και είναι ζεστό.
- Λοιμώξεις των οστών: Αυτές οι λοιμώξεις μπορεί να επιφέρουν πόνο, πρήξιμο, ερυθρότητα και αποχρωματισμό στην περιοχή της λοίμωξης. Μπορούν επίσης να προκαλέσουν πυρετό και ρίγη.
- Ενδοκαρδίτιδα: Η ενδοκαρδίτιδα είναι μια λοίμωξη του βλεννογόνου της καρδιάς. Δημιουργεί συμπτώματα που μοιάζουν με γρίπη, όπως πυρετός, κόπωση, ρίγη, γρήγορος καρδιακός παλμός και δύσπνοια. Μπορεί επίσης να προκαλέσει συσσώρευση υγρών στα χέρια και τα πόδια.
- Τροφική δηλητηρίαση: Η τροφική δηλητηρίαση προκαλεί ναυτία, εμετό, διάρροια, πυρετό και πιθανή αφυδάτωση.
- Πνευμονία: Αυτή η λοίμωξη των πνευμόνων προκαλεί υψηλό πυρετό, βήχα, ρίγη, πιθανό πόνο στο στήθος και δύσπνοια.
- TSS: Το TSS προκαλεί ξαφνική πτώση της αρτηριακής πίεσης, υψηλό πυρετό, εμετό, διάρροια και σύγχυση. Μπορεί επίσης να αναπτυχθεί εξάνθημα που μοιάζει με ηλιακό έγκαυμα.
Όταν ένας γιατρός υποπτεύεται μια μόλυνση από σταφυλόκοκκο, θα κάνει στο άτομο ερωτήσεις σχετικά με τα συμπτώματά του και μπορεί να κάνει μια εξέταση αίματος ή μια καλλιέργεια του προσβεβλημένου δέρματος. Εάν υποπτεύεται σταφυλόκοκκο, θα επιδιώξει να ξεκινήσει γρήγορα θεραπεία για να αποφύγει περαιτέρω ασθένεια.
Αιτίες
Η αιτία της μόλυνσης από σταφυλόκοκκο είναι τα βακτήρια του σταφυλόκοκκου που εισέρχονται στον οργανισμό. Αυτό μπορεί να συμβεί ως αποτέλεσμα:
- σκαλίζοντας ή ξύνοντας σπυράκια, πληγές ή εξογκώματα στο δέρμα
- ερχόμενοι σε επαφή με κάποιον άλλο που έχει σταφυλόκοκκο
- ευρισκόμενοι σε κατάσταση που τους εκθέτει σε μεγάλο βαθμό στα βακτήρια, όπως μια χειρουργική επέμβαση ή μια παραμονή στο νοσοκομείο
- μοιράζοντας προσωπικά αντικείμενα, όπως πετσέτες, ξυραφάκια ή μακιγιάζ, με κάποιον που έχει τη μόλυνση
- αποκτώντας τα βακτήρια από κοινές επιφάνειες, όπως εξοπλισμό γυμναστηρίου
Οι άνθρωποι μπορούν να λάβουν μέτρα για να προστατευθούν από τη μόλυνση από τα βακτήρια σταφυλόκοκκου. Σε αυτά περιλαμβάνονται:
- το σχολαστικό πλύσιμο των χεριών με σαπούνι και ζεστό νερό
- την κάλυψη κοψιμάτων και γρατζουνιών με στεγνούς, καθαρούς επιδέσμους
- το στέγνωμα των ρούχων σε ζεστό στεγνωτήριο, το οποίο σκοτώνει τα βακτήρια
- την τακτική απολύμανση των κοινόχρηστων επιφανειών
Θεραπείες
Οι θεραπευτικές επιλογές εξαρτώνται από τον τύπο και τη σοβαρότητα της μόλυνσης από σταφυλόκοκκο. Οι περισσότερες θεραπευτικές αγωγές περιλαμβάνουν αντιβιοτικά.
Ανάλογα με τον τύπο της λοίμωξης, ο γιατρός μπορεί να συνταγογραφήσει:
- αντιβιοτικά από το στόμα
- κρέμες ή αλοιφές
- ενδοφλέβια αντιβιοτικά
Σε πολλές περιπτώσεις, αυτό θα είναι αρκετό για τη θεραπεία της λοίμωξης. Ωστόσο, σε άλλες περιπτώσεις μπορεί να χρειαστούν και άλλες παρεμβάσεις.
Για παράδειγμα, εάν μια δερματική λοίμωξη από σταφυλόκοκκο περιλαμβάνει συσσώρευση πύου, μπορεί να χρειαστεί παροχέτευση. Οι λοιμώξεις από σταφυλόκοκκο που εξαπλώνονται στα οστά και σε άλλους εσωτερικούς ιστούς μπορεί να απαιτούν χειρουργική επέμβαση.
Οι γιατροί δεν συνταγογραφούν αντιβιοτικά για τη θεραπεία της τροφικής δηλητηρίασης από σταφυλόκοκκο. Η σοβαρή ασθένεια είναι σπάνια, αλλά ορισμένα άτομα μπορεί να χρειαστούν ενδοφλέβια υγρά για την αφυδάτωση από επίμονο εμετό ή διάρροια.
Παράγοντες κινδύνου
Ορισμένοι άνθρωποι έχουν αυξημένο κίνδυνο για λοιμώξεις από σταφυλόκοκκο. Σε αυτά τα άτομα περιλαμβάνονται εκείνοι που:
- έχουν υποβληθεί σε χειρουργική επέμβαση
- έχουν αναπνευστικό σωλήνα ή σωλήνα σίτισης ή καθετήρα
- υποβάλλονται σε αιμοκάθαρση
- κάνουν ενέσεις ναρκωτικών
- έχουν χρόνια πάθηση, όπως διαβήτη, καρκίνο, έκζεμα, πνευμονοπάθεια ή αγγειακή νόσο
- έχουν εξασθενημένο ανοσοποιητικό σύστημα
- παίζουν αθλήματα επαφής που περιλαμβάνουν επαφή δέρμα με δέρμα
Τα άτομα που διατρέχουν υψηλότερο κίνδυνο πρέπει να φροντίζουν να πλένουν τα χέρια τους σχολαστικά και τακτικά και να αποστειρώνουν τις κοινόχρηστες επιφάνειες όποτε είναι δυνατόν.
Μπορεί επίσης να επιθυμούν να αποφεύγουν την κοινή χρήση προσωπικών αντικειμένων, όπως πετσέτες, πανιά και αθλητικό εξοπλισμό.
Ανάρρωση
Ο χρόνος ανάρρωσης μιας λοίμωξης από σταφυλόκοκκο εξαρτάται από τον τύπο και τη σοβαρότητα της λοίμωξης, καθώς και από τη δύναμη του ανοσοποιητικού συστήματος του ατόμου.
Η τροφική δηλητηρίαση από σταφυλόκοκκο συνήθως περνά μέσα σε 24 έως 48 ώρες, αλλά μπορεί να χρειαστούν 3 ημέρες ή και περισσότερο για να αισθανθείτε καλά.
Μια μόλυνση από σταφυλόκοκκο στην επιφάνεια του δέρματος μπορεί να επουλωθεί με θεραπεία λίγων μόνο ημερών. Ωστόσο, εάν έχει αναπτυχθεί μια μεγάλη πληγή ή τραύμα, μπορεί να χρειαστούν αρκετές εβδομάδες θεραπείας ή και περισσότερο.
Εάν αναπτυχθεί συστηματική λοίμωξη από σταφυλόκοκκο στην καρδιά, τους πνεύμονες, την κυκλοφορία του αίματος ή άλλο οργανικό σύστημα, η θεραπεία μπορεί να διαρκέσει εβδομάδες έως μήνες.
Σε σπάνιες περιπτώσεις, αυτές οι λοιμώξεις από σταφυλόκοκκο μπορεί να οδηγήσουν σε σήψη, μια επικίνδυνη κατάσταση κατά την οποία το ανοσοποιητικό σύστημα έχει υπερβολική αντίδραση στη λοίμωξη.
Συνοψίζοντας
Είναι φυσιολογικό τα βακτήρια σταφυλόκοκκου να ζουν στο δέρμα και στη μύτη ορισμένων ανθρώπων. Προβλήματα δημιουργούνται μόνο όταν τα βακτήρια σταφυλόκοκκου εισέρχονται στο σώμα μέσω μιας τομής, μιας πληγής ή ενός μολυσμένου τροφίμου, όταν μπορούν να οδηγήσουν σε μόλυνση.
Οι άνθρωποι που ζουν, εργάζονται ή αθλούνται κοντά με άλλους και όσοι πάσχουν από ορισμένες παθήσεις έχουν μεγαλύτερο κίνδυνο να υποστούν λοιμώξεις από σταφυλόκοκκο. Η παραμονή στο νοσοκομείο ή η χειρουργική επέμβαση αυξάνει επίσης τον κίνδυνο μόλυνσης από σταφυλόκοκκο.
Ένα άτομο με συμπτώματα μόλυνσης από σταφυλόκοκκο θα πρέπει να αναζητήσει θεραπεία για να αποφύγει επιπλοκές. Τα άτομα που έχουν εξασθενημένο ανοσοποιητικό σύστημα θα πρέπει να μιλήσουν με γιατρό μόλις υποψιαστούν ότι έχουν λοίμωξη.